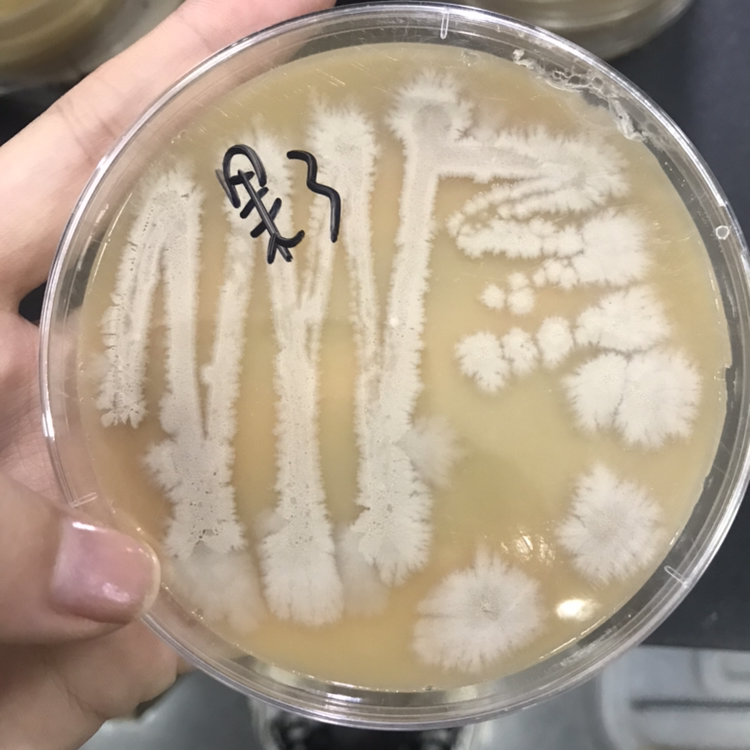
醋酸菌醋酸菌鉴定拜托大家了

醋酸菌
醋酸菌
图片尺寸1200x857醋酸菌
图片尺寸1200x857醋酸菌
图片尺寸1200x857
醋酸菌图册_百度百科
图片尺寸500x392醋酸菌
图片尺寸1200x857
醋酸菌
图片尺寸300x222醋酸菌
图片尺寸600x400
帝伯仕醋酸菌果醋菌10g 自酿水果醋葡萄醋苹果醋酿醋曲
图片尺寸800x800
菌落
图片尺寸3024x4032
醋酸菌醋酸菌鉴定拜托大家了
图片尺寸750x750
醋酸菌醋酸菌鉴定拜托大家了
图片尺寸750x750
醋酸菌是原核生物吗「知识普及」
图片尺寸1024x768醋酸菌
图片尺寸1200x857
a.酵母菌,乳酸
图片尺寸302x431
醋酸菌的生长要求
图片尺寸930x868
显微镜下的世界
图片尺寸1200x953
一种耐热醋酸菌及其应用的制作方法
图片尺寸1000x911
经历季节的变化,形成白白的醋菌膜,已发酵成醋了,但要等醋出缸,工艺却
图片尺寸1082x722
醋酸菌是原核生物吗「知识普及」
图片尺寸2012x2462
基于工程教育专业认证的《发酵工程》课程综合改革探索
图片尺寸440x334